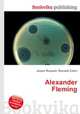
Alexander Fleming, Jesse Russell,Ronald Cohn

Поиск книг, учебников, пособий в онлайн-магазинах
Найдено 3827822, cтраницы: ← | 1 ... 78138 78139 78140 78141 · 78142 · 78143 78144 78145 78146 ... 318986 | →
Religious relations in Israel
High Quality Content by WIKIPEDIA articles! Religious relations in Israel are re...
Автор: Jesse Russell,Ronald Cohn, 154 стр., издатель: "Книга по Требованию", ISBN: 978-5-5093-3327-9
High Quality Content by WIKIPEDIA articles! Religious relations in Israel are re...
2009–10 Syracuse Orange men's basketball team
High Quality Content by WIKIPEDIA articles! The 2009–10 Syracuse Orange men's ba...
Автор: Jesse Russell,Ronald Cohn, 107 стр., издатель: "Книга по Требованию", ISBN: 978-5-5093-3326-2
High Quality Content by WIKIPEDIA articles! The 2009–10 Syracuse Orange men's ba...
Middlesex County Council elections
High Quality Content by WIKIPEDIA articles! Middlesex County Council was the pri...
Автор: Jesse Russell,Ronald Cohn, 109 стр., издатель: "Книга по Требованию", ISBN: 978-5-5093-3325-5
High Quality Content by WIKIPEDIA articles! Middlesex County Council was the pri...
Alexander Fleming
High Quality Content by WIKIPEDIA articles! Sir Alexander Fleming, FRSE, FRS, FR...
Автор: Jesse Russell,Ronald Cohn, 109 стр., издатель: "Книга по Требованию", ISBN: 978-5-5093-3324-8
High Quality Content by WIKIPEDIA articles! Sir Alexander Fleming, FRSE, FRS, FR...
National Register of Historic Places listings in Essex County, New York
High Quality Content by WIKIPEDIA articles! List of the National Register of His...
Автор: Jesse Russell,Ronald Cohn, 100 стр., издатель: "Книга по Требованию", ISBN: 978-5-5093-3323-1
High Quality Content by WIKIPEDIA articles! List of the National Register of His...
0 (number)
High Quality Content by WIKIPEDIA articles! 0 (zero; BrE: /?z??r??/, ZIRR-oh or ...
Автор: Jesse Russell,Ronald Cohn, 105 стр., издатель: "Книга по Требованию", ISBN: 978-5-5093-3322-4
High Quality Content by WIKIPEDIA articles! 0 (zero; BrE: /?z??r??/, ZIRR-oh or ...
Kollam district
High Quality Content by WIKIPEDIA articles! Kollam district (formerly Quilon) is...
Автор: Jesse Russell,Ronald Cohn, 148 стр., издатель: "Книга по Требованию", ISBN: 978-5-5093-3321-7
High Quality Content by WIKIPEDIA articles! Kollam district (formerly Quilon) is...
Cars (franchise)
High Quality Content by WIKIPEDIA articles! Cars is the second franchise created...
Автор: Jesse Russell,Ronald Cohn, 111 стр., издатель: "Книга по Требованию", ISBN: 978-5-5093-3320-0
High Quality Content by WIKIPEDIA articles! Cars is the second franchise created...
List of world junior records in athletics
High Quality Content by WIKIPEDIA articles! World Junior Records in the sport of...
Автор: Jesse Russell,Ronald Cohn, 129 стр., издатель: "Книга по Требованию", ISBN: 978-5-5093-3319-4
High Quality Content by WIKIPEDIA articles! World Junior Records in the sport of...
2011–12 GNK Dinamo Zagreb season
High Quality Content by WIKIPEDIA articles! This article shows statistics of ind...
Автор: Jesse Russell,Ronald Cohn, 105 стр., издатель: "Книга по Требованию", ISBN: 978-5-5093-3318-7
High Quality Content by WIKIPEDIA articles! This article shows statistics of ind...
1999 French Open – Men's Singles
High Quality Content by WIKIPEDIA articles! Carlos Moya was the defending champi...
Автор: Jesse Russell,Ronald Cohn, 119 стр., издатель: "Книга по Требованию", ISBN: 978-5-5093-3317-0
High Quality Content by WIKIPEDIA articles! Carlos Moya was the defending champi...
List of ATP Tour Grand Slam tournaments and Masters singles champions
High Quality Content by WIKIPEDIA articles! This is a list of the men's singles ...
Автор: Jesse Russell,Ronald Cohn, 122 стр., издатель: "Книга по Требованию", ISBN: 978-5-5093-3316-3
High Quality Content by WIKIPEDIA articles! This is a list of the men's singles ...
Найдено 3827822, cтраницы: ← | 1 ... 78138 78139 78140 78141 · 78142 · 78143 78144 78145 78146 ... 318986 | →